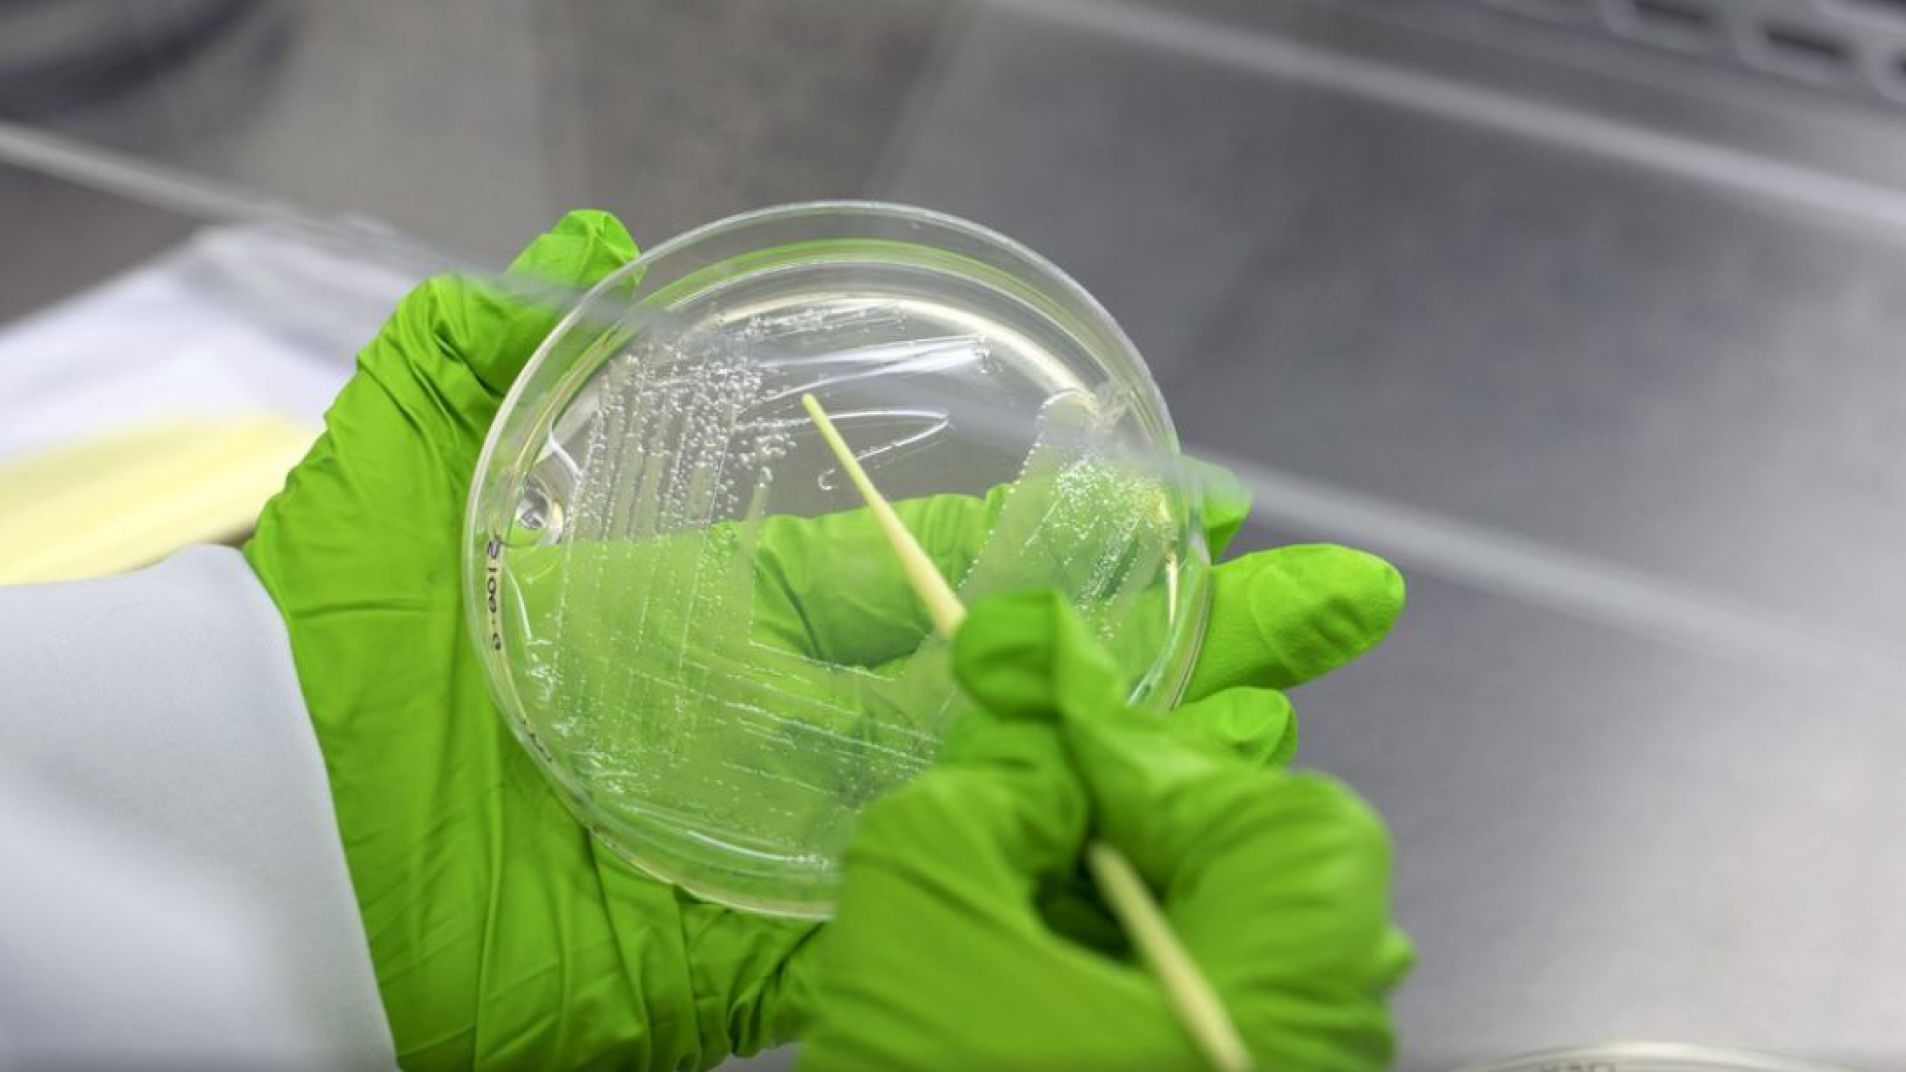
Suba de muertes por infecciones que ahora resisten a los antibióticos

La resistencia antimicrobiana (RAM) es uno de los grandes temas de salud pública de los últimos años y ocupa un lugar cada vez más destacado en las preocupaciones médicas. Un nuevo artículo que acaba de publicar este lunes la revista The Lancet redobla la alarma por la impotencia de la ciencia para responder a bacterias que se vuelven cada vez más peligrosas debido al abuso de antibióticos.
El trabajo, realizado sobre la base de estimaciones en 204 países, se denomina "Carga mundial de la resistencia bacteriana a los antimicrobianos 1990- 2021: un análisis sistemático con previsiones hasta 2050". Se trata de una investigación llevada adelante por el Proyecto de investigación global sobre la resistencia a los antimicrobianos (GRAM), y sugiere que la resistencia bacteriana causará 39 millones de muertes entre 2025 y 2050, lo que equivale a tres muertes cada minuto.
El estudio, de científicos de la University of Washington School of Medicine, prevé un aumento del 67,5 por ciento de las muertes anuales atribuidas directamente a la RAM bacteriana, al pasar de 1,14 millones en 2021 a una cifra estimada de 1,91 millones en 2050. También se espera que las muertes asociadas a la RAM aumenten un 74,5 por ciento, de 4,71 millones en 2021 a 8,22 millones de muertes en 2050.
"La resistencia bacteriana a los antimicrobianos se produce cuando las bacterias cambian de forma que ya no responden a los medicamentos. De este modo, la gente muere de infecciones comunes como neumonía, infecciones del tracto urinario y diarrea porque las bacterias se han vuelto resistentes al tratamiento", explican los investigadores en el trabajo publicado.
El proyecto GRAM pertenece a la Asociación Estratégica Universidad de Oxford-IHME, financiado por el Fondo Fleming del Departamento de Sanidad y Asistencia Social del Reino Unido y Wellcome. En 2022 se publicó el primer conjunto de datos sobre la carga de muertes por RAM, que dio cuenta de que por este motivo había habido desde 1990 más de un millón de muertes por año, para totalizar 36 millones.
"Entre los distintos tipos de infecciones resistentes a los antibióticos, el Staphylococcus aureus resistente a la meticilina (SARM) fue el responsable del mayor aumento de muertes entre 1990 y 2021. Las muertes por SARM se duplicaron con creces durante este periodo", explica la publicación.
El artículo se publicó en vísperas de la Reunión de Alto Nivel de la Asamblea General de las Naciones Unidas (AGNU) sobre la RAM, que se celebrará a fines de septiembre y reunirá a los líderes mundiales para debatir la repercusión de la RAM en la salud y la economía mundiales y acordar medidas colectivas.
El impacto de la resistencia antimicrobiana
Por primera vez, las estimaciones muestran que la RAM representa la mayor amenaza para los adultos mayores, ya que las muertes en adultos de 70 años o más aumentaron en más del 80 por ciento entre 1990 y 2021. Esto sugiere que el impacto de la RAM crecerá aún más con el tiempo debido al rápido envejecimiento de la población, que es más vulnerable a las infecciones.
"Además de causar muertes, la RAM ejerce presión sobre los sistemas sanitarios vulnerables y las economías nacionales, creando la necesidad de cuidados más caros e intensivos, además de contribuir a una pérdida del PIB de entre 1 y 3,4 billones de dólares al año hasta el año 2030", agrega el trabajo.
En este contexto dramático, una buena noticia es que desde 1990 las muertes por RAM entre los niños menores de 5 años han disminuido rápidamente, al pasar de 488.000 en 1990 a 193.000 en 2021. Sin embargo, el estudio sugiere que esto no obedece a una reducción de la prevalencia de la RAM, sino a los éxitos en la reducción de la incidencia de infecciones infantiles graves, por ejemplo, mediante programas de vacunación que incluyen la utilización de vacunas antineumocócicas conjugadas y la mejora del acceso al agua potable, el saneamiento y la higiene.
La investigación publicada en The Lancet también indica que las inversiones en asistencia sanitaria para mejorar la atención de las infecciones graves y el acceso a los antimicrobianos podrían salvar hasta 92 millones de vidas de aquí al año 2050, mientras que la "liberación periódica de nuevos antimicrobianos dirigidos a los patógenos GRAM negativos podría evitar hasta 11 millones de muertes relacionadas con la RAM".
El artículo identifica algunas posibles soluciones que pueden impulsar el progreso contra la RAM: 1) Acelerar las medidas de prevención y control, ampliando el acceso a nuevos antibióticos y vacunas; 2) Mejorar la calidad de la atención sanitaria en hospitales y centros de salud, concretamente aumentando la capacidad de diagnóstico. 3) Los gobiernos y el sector privado deben crear incentivos y aumentar la financiación en todas las fases del proceso de desarrollo de nuevos antibióticos contra bacterias farmacorresistentes como E. coli y K. Pneumoniae.
"Si bien la lucha contra la resistencia bacteriana se lleva a cabo a nivel local, principalmente en los sistemas sanitarios y en las comunidades, es necesaria una actuación urgente por parte de los líderes mundiales para garantizar un progreso más rápido y un mayor impacto global", reclaman los científicos.
Christopher Murray, director del Instituto de Evaluación de Métricas Sanitarias y responsable del estudio GRAM, explicó: "Las nuevas estimaciones indican que la RAM siempre ha sido, y sigue siendo, una amenaza urgente para la salud mundial. Utilizando las estimaciones proporcionadas en el informe de la GRAM, los responsables políticos pueden aprovechar la toma de decisiones basada en datos para abordar eficazmente esta crisis".
En Argentina existe desde 2022 -con reglamentación en 2023- la Ley 27.680 de Prevención y Control de la Resistencia Antimicrobiana, que dispuso más exigencias para la comercialización de antibióticos y además formalizó la creación del Plan Nacional para la Prevención y Control de la Resistencia a los Antimicrobianos y busca combatir la resistencia antimicrobiana de forma coordinada con el involucramiento de todos los actores de la salud pública del país.